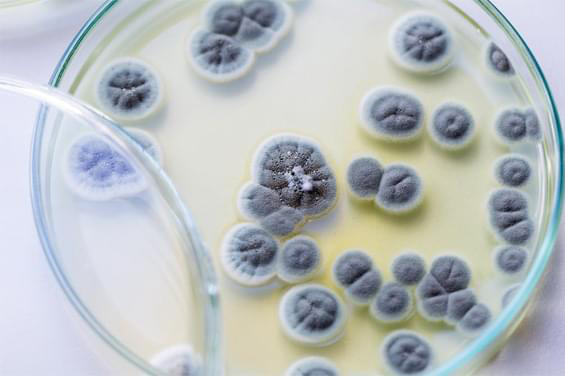

Протисудомні препарати
У лікуванні патологій, що протікають у супроводі судомного синдрому, протисудомні препарати найчастіше застосовуються як етіотропи. Різноманітність антиконвульсантів на фармацевтичному ринку дає можливість вибрати ефективний фармзасіб із мінімальною кількістю побічних дій.
Як діють протисудомні препарати?

Вплив антиконвульсантних медзасобів на нейрони головного мозку пов'язаний із такими ефектами:
-
пригніченням вивільнення глутамату з нервових закінчень (Ламотрін);
-
блокадою NMDA-рецепторів (Вальпроком);
-
деполяризацією нейронів за рахунок взаємодії з ГАМК-А-рецепторним комплексом (похідні барбітурової кислоти та бензодіазепіни);
-
блокадою зворотного захоплення ГАМК та її стабілізацією у синаптичній щілині (Неогабін);
-
гальмуванням поширення електричного імпульсу внаслідок інактивації кальцієвих та натрієвих каналів (Карбамазепін, Вальпроком);
-
блокадою Т-кальцієвих каналів (похідні етосуксиміду).
Показання до призначення
Судомами називають мимовільні скорочення м'язових волокон. Їхнє виникнення не завжди є симптомом патології. Нерідко такі посмикування спостерігаються внаслідок надмірної напруги окремих груп м'язів (наприклад, при заняттях спортом). Спастичні скорочення також можливі під час перебування у холодній воді. Проте синдром може свідчити і про розвиток важкого захворювання.
Насамперед призначення антиконвульсантних фармліків показано в лікувальній схемі генуїнної (ідіопатичної) епілепсії. Причину цієї хвороби сьогодні не встановлено. Внаслідок надмірного аномального розряду нейронів головного мозку виникають тонічні та клонічні конвульсії, що супроводжуються втратою свідомості (генералізований епілептичний напад). Крім розгорнутих судомних нападів, хвороба проявляється безсудомними нападами, специфічними змінами особистості, сутінковими розладами, вегетативною дисфункцією.
Про симптоматичну (вторинну) форму хвороби говорять у тих випадках, коли причина її розвитку відома. Приймання протисудомних засобів рекомендується фахівцями різних профілів у таких випадках:
-
Аномалії церебральних судин (ішемічний та геморагічний інсульт, дисциркуляторна енцефалопатія), у тому числі пов'язана з віковими змінами.
-
Перенесені ЧМТ (гострий та віддалений період).
-
Нейроінфекції, що призводять до ураження речовини головного мозку та мозкових оболонок (менінгококова інфекція, токсоплазмоз, ВІЛ-інфекція).
-
Ниркова та печінкова недостатність, що супроводжується обмінними та водно-електролітними порушеннями.
-
Ендокринні захворювання (гіпопаратиреоз, гіпертиреоз).
-
Неврологічні відхилення, при яких спостерігаються хаотичні рухи та судомні посмикування м'язів. Серед них – хвороба Паркінсона, хорея Гентінгтона.
-
Об'ємні процеси головного мозку (пухлина, гематома).
У наркологічній практиці епілептичний синдром розвивається при тяжкому алкогольному сп'янінні, вживанні психомоторних стимуляторів (амфетаміни, кокаїн). Припадки у структурі алкогольного похмільного синдрому вважаються поганою прогностичною ознакою та сигналізують про обтяження стану хворого.
Судомні м'язові посмикування можливі при токсикозах вагітних (еклампсія), у дітей при підвищенні температури тіла понад +38,5°C. Призначати ліки проти судом у м'язах можна лише після встановлення діагнозу. Своєчасне визначення етіології конвульсій дозволяє розробити оптимальну терапевтичну схему у кожному окремому випадку.
Не варто забувати й про інші властивості антиконвульсантів: завдяки своєму впливу на емоційну сферу деякі представники цієї групи успішно застосовуються в терапії тривожних розладів і маніакально-депресивного психозу. Крім того, вони рекомендовані для усунення нейропатичного болю, який виникає при ураженні нервів. Ряд медикаментів з антиконвульсивною активністю використовується з метою седації та покращення сну.
Застосування у педіатрії

Необхідність приймання антиконвульсантних фармліків дітьми залежить від першопричини конвульсій та частоти їх виникнення. Зазвичай при одноразовому нападі вони не призначаються. Антисудомні медпрепарати рекомендуються при повторенні спазматичних нападів, високому ризику пошкодження головного мозку або смерті при генералізованих нападах.
Найчастіше у педіатричній практиці використовуються:
-
Вальпроком та інші вальпроати;
-
Фенітоїн;
-
Леветирацетам;
-
Карбамазепін;
-
Ламотрін;
-
Топірамат;
-
Фелбамат;
-
Етосуксимід.
Крім таблеток, педіатричні засоби для зручності приймання випускаються у вигляді сиропів та спеціальних гранул.
Протисудомні ліки при м'язових конвульсіях ніг
Поява м'язових спазмів нижніх кінцівок, що супроводжуються гострим болем, пов'язана з низкою факторів:
-
Тривале перебування у некомфортній позі («затерпла нога»), переохолодження, різка зміна положення тіла лежачої людини — спазми пов'язані зі стисканням нервових волокон та звуженням просвіту кровоносних судин.
-
Варикозне розширення вен нижніх кінцівок – конвульсії виникають внаслідок застою крові, зумовленого зниженням тонусу в поверхневих та глибоких венах.
-
Дефіцит мікроелементів (кальцій, калій, магній) та вітаміну D3 – м'язові посмикування в литковій ділянці виникають як наслідок порушення реологічних властивостей крові та спазмування артерій.
-
Незбалансований раціон. Появі спазмів сприяють голодування, надлишок у меню тваринного білка, низьковуглеводні дієти, що призводить до ацидозу та вимивання кальцію. Зловживання кухонною сіллю при дефіциті кальцію може спричинити спазм судин і затримку рідини.
-
Захворювання опорно-рухового апарату, що супроводжуються затисканням нервів. М'язові спазми нижніх кінцівок можуть спостерігатися у пацієнтів із деформацією стоп, поперековим стенозом, перенесеними травмами хребта та ніг.
-
Патологія ЦНС (злоякісні новоутворення, епілептичні напади, нейроінфекції, тяжкі ЧМТ тощо).
-
Гормональний дисбаланс, що призводить до прискореного виведення мікроелементів (гіпотиреоз, цукровий діабет, гіпофункція надниркових залоз).
-
Стреси, надлишкові фізичні навантаження – кортизол, що виділяється при цьому, перешкоджає засвоюваності кальцію в кишківнику та негативно позначається на загальному самопочутті.
-
Застосування діуретиків, аналептиків, статинів, психостимуляторів.
-
Зловживання кофеїном, тютюнопаління.

М'язові спазми в ногах у вагітних пов'язані зі зниженням рівня кальцію в крові та венозним застоєм. Період активного зростання у дітей нерідко супроводжується хворобливими скороченнями м'язів нижніх кінцівок. Спастичний біль у гомілках у літніх часто є симптомом остеохондрозу, облітеруючого ендартеріїту, варикозного розширення вен, захворювань внутрішніх органів.
Вибір ліків від судом у ногах залежить від причини їх виникнення. Так, наприклад:
-
венотоніки показані при лімфовенозній недостатності;
-
антиконвульсанти та міорелаксанти ефективні, якщо м'язові посмикування спровоковані патологією нервової системи;
-
нестероїдні протизапальні засоби покращують реологічні властивості крові, що запобігає спазму надалі;
-
мінерали та вітаміни призначаються при їх дефіциті (зазвичай у поєднанні з медикаментами інших груп).
Особливості застосування
Лікувальна схема (вид антиконвульсанту, його дозування, спосіб введення, тривалість терапії) залежить від етологічного фактору, що призвів до розвитку судомного синдрому. При генуїнній епілепсії протисудомні засоби, препарати слід приймати тривалий проміжок часу. Регулярне приймання медикаментів допомагає знизити частоту конвульсій та значно покращити якість життя хворого.
Необхідно пам'ятати, що коригувати дозу та скасовувати медпрепарат може тільки лікар. Відмова від його використання загрожує розвитком генералізованого нападу (аж до епілептичного статусу) та інших небезпечних для життя станів, тому його скасування здійснюється під суворим контролем фахівця.
При симптоматичній епілепсії її прояви нерідко зникають під час усунення основного захворювання. Зазвичай у таких випадках антиконвульсанти приймаються короткими курсами в якості симптоматичної терапії.
Негативні реакції
Імовірність виникнення побічних ефектів обумовлена діючою речовиною медикаменту, його дозуванням, тривалістю застосування, а також індивідуальною реакцією хворого на ліки проти судом. Нерідко пацієнти не помічають якихось негативних впливів антиконвульсивного фармзасобу на організм навіть при тривалій терапії.
Як правило, неприємні відчуття виникають на початковому етапі лікування або за умов зміни його схеми. Найчастіше пацієнтів турбують такі симптоми:
-
нудота;
-
запаморочення, хиткість ходи;
-
підвищена втома, сонливість;
-
збільшення маси тіла чи, навпаки, втрата ваги;
-
периферичні набряки;
-
випадання волосся;
-
порушення менструального циклу;
-
пронос, біль у животі;
-
гіперактивність у дітей, зниження концентрації уваги;
-
втрата поля зору тощо.
Можливі зміни у загальному клінічному аналізі крові (анемія, тромбоцитопенія).
Деякі побічні ефекти є оборотними та легко піддаються корекції. Наприклад, позбутися зайвої ваги можна за допомогою фізичних вправ та збалансованого харчування. Незначне схуднення компенсується підвищенням енергетичної цінності продуктів. Втома, сонливість проходять при додаванні до раціону харчових добавок і вітамінів.
Вкрай рідко використовуються антиконвульсантні фармзасоби з незворотними побічними діями. Вони показані при тяжких епілептичних формах, коли ризик розвитку загрозливого життю стану вищий, ніж ймовірність появи побічних реакцій від приймання ліків для лікування судом. Якщо під час терапевтичного курсу з'явилися шкірні висипання, темна сеча, аритмія, носова кровотеча, виражений біль голови, сплутаність свідомості, необхідно терміново звернутися до лікаря.
Хворі повинні відповідально ставитися до свого здоров'я та позбавлення від судомних розладів. Щоб уникнути небезпечних наслідків при вживанні антиконвульсантів, слід дотримуватись таких рекомендацій:
-
При призначенні медичного препарату обговоріть з фахівцем план терапії, можливі побічні ефекти та способи їх усунення.
-
Чітко виконуйте всі приписи лікаря, дотримуйтесь призначеної схеми.
-
Щоб вчасно діагностувати негативні реакції, потрібно регулярно відвідувати свого лікаря та складати лабораторні аналізи.
-
Якщо неприємні симптоми все ж таки виникли, категорично заборонено займатися самолікуванням і припиняти приймати протисудомні лікарські засоби.
Де придбати ефективні медикаменти?

На сайті «Online Аптека» клієнти нашого інтернет-магазину можуть ознайомитися з каталогом товарів та купити якісні фармпрепарати для боротьби з епілепсією та іншими захворюваннями, що супроводжуються м'язовими посмикуваннями. В онлайн-аптеці в наявності є протисудомні препарати при судомах для дорослих і дітей, що випускаються вітчизняними та закордонними брендами. Вартість ліцензованих товарів істотно нижча, ніж при покупці в аптечній мережі.
Перед замовленням ліків, протисудомних препаратів в «Online Аптека» можна ознайомитись з інструкцією до них на сайті магазину, почитати відгуки клієнтів щодо ефективності препарату, замовити дзвінок та отримати консультацію менеджера. Однак оптимальним варіантом перед покупкою буде звернення до лікаря.